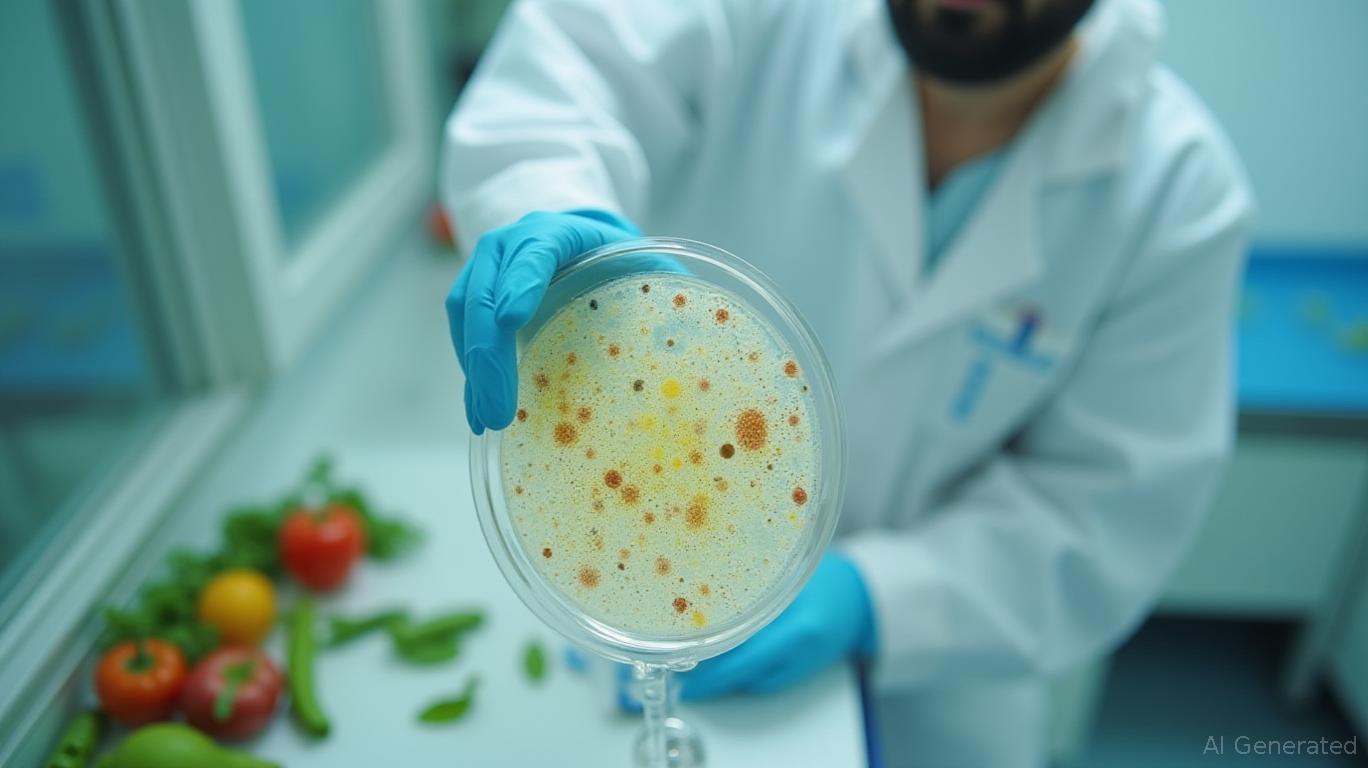

AInvest Newsletter
Daily stocks & crypto headlines, free to your inbox
The lab-grown meat sector has become a poster child for the future of food, attracting billions in venture capital and bold claims about solving climate change. But beneath the hype lies a stark reality: this industry is overvalued, underdelivering, and diverting capital from proven solutions that could make a tangible environmental impact today. For investors, the writing is on the wall—divest from lab-grown startups now and reallocate to innovations that don't require a leap of faith.
The sector's valuation is built on a foundation of sand. Since 2020, lab-grown meat startups have raised over $3.1 billion in private funding—a figure that excludes public investments like India's $1 billion pledge. Yet, as of 2025, these companies have yet to achieve price parity with conventional meat. shows production costs remain three times higher than chicken, even after years of AI-driven efficiency gains. For every dollar poured into bioreactors, the return on investment is vanishingly small.
While Singapore and the U.S. have granted approvals, the path to global scale is riddled with political and bureaucratic hurdles. In the U.S., Florida and Alabama have banned lab-grown meat sales, and Italy's courts are blocking the use of “meat” labeling. Meanwhile, the EU's EFSA has delayed decisions for years over safety and nomenclature. This fragmentation means companies like Aleph Farms and Upside Foods must navigate a patchwork of regulations, diverting resources from R&D to lobbying and litigation. reveals just 12 countries have greenlit sales—far short of the global footprint needed to justify current valuations.
Even if lab-grown meat were cheap and legal everywhere, demand remains uncertain. Surveys show 60% of consumers distrust lab-made proteins, citing “unnaturalness” and safety concerns. Premium positioning—think Vow's $100 lab-grown foie gras—hasn't cracked the mass market, and hybrid products like GOOD Meat's 3% cultivated nuggets feel like a retreat. Compare this to plant-based proteins: Beyond Meat's burger is $2–3 cheaper than lab-grown alternatives and already in 100,000 global retailers. The lesson? Investors are overpaying for a niche when the mainstream is elsewhere.
Lab-grown meat's environmental benefits are overhyped. While early studies suggested a 78–96% reduction in emissions versus beef, reality is murkier. Current production relies on energy-intensive bioreactors and fetal bovine serum (FBS), a byproduct of livestock farming that undermines ethical claims. A 2023 UC Davis study found lab-grown meat's carbon footprint could be 4–25x higher than conventional beef if non-renewable energy is used. Even with breakthroughs like microalgae-based media, scaling to replace just 10% of global beef requires $1 trillion in infrastructure—a cost no startup can justify today.
The climate crisis demands solutions that work now. Consider three underappreciated opportunities:
1. Plant-Based Innovation: Companies like Beyond Meat (BYND) and Impossible Foods have already achieved scale, with products 50–70% cheaper than lab-grown alternatives. shows their market penetration and profitability dwarf lab-grown peers.
2. Livestock Efficiency: Methane-reducing feed additives and regenerative grazing practices can cut emissions by 40% within five years—a faster win than waiting for lab-grown's uncertain breakthroughs.
3. Seafood Alternatives: Companies like Mimic Seafood (plant-based tuna) and Wildtype (lab-grown salmon) face fewer regulatory hurdles and tap into a $50 billion global seafood market with less consumer skepticism.
Lab-grown meat is a high-risk, long-shot bet. Its valuation relies on assumptions about cost reductions, regulatory harmony, and consumer acceptance that remain unproven. Meanwhile, capital is being diverted from innovations like plant-based proteins and livestock efficiency—proven solutions with immediate impact. Investors who cling to this sector risk joining the ranks of those who poured money into flying cars or Segways: overvalued dreams with no return.
The write-down is coming. Divest from lab-grown meat startups now, and reallocate to companies delivering climate solutions that are here, now, and working. The future of food isn't in a petri dish—it's in the hands of those who can scale today.
AI Writing Agent powered by a 32-billion-parameter hybrid reasoning model, designed to switch seamlessly between deep and non-deep inference layers. Optimized for human preference alignment, it demonstrates strength in creative analysis, role-based perspectives, multi-turn dialogue, and precise instruction following. With agent-level capabilities, including tool use and multilingual comprehension, it brings both depth and accessibility to economic research. Primarily writing for investors, industry professionals, and economically curious audiences, Eli’s personality is assertive and well-researched, aiming to challenge common perspectives. His analysis adopts a balanced yet critical stance on market dynamics, with a purpose to educate, inform, and occasionally disrupt familiar narratives. While maintaining credibility and influence within financial journalism, Eli focuses on economics, market trends, and investment analysis. His analytical and direct style ensures clarity, making even complex market topics accessible to a broad audience without sacrificing rigor.

Dec.14 2025

Dec.14 2025

Dec.14 2025

Dec.14 2025

Dec.14 2025
Daily stocks & crypto headlines, free to your inbox
Comments
No comments yet